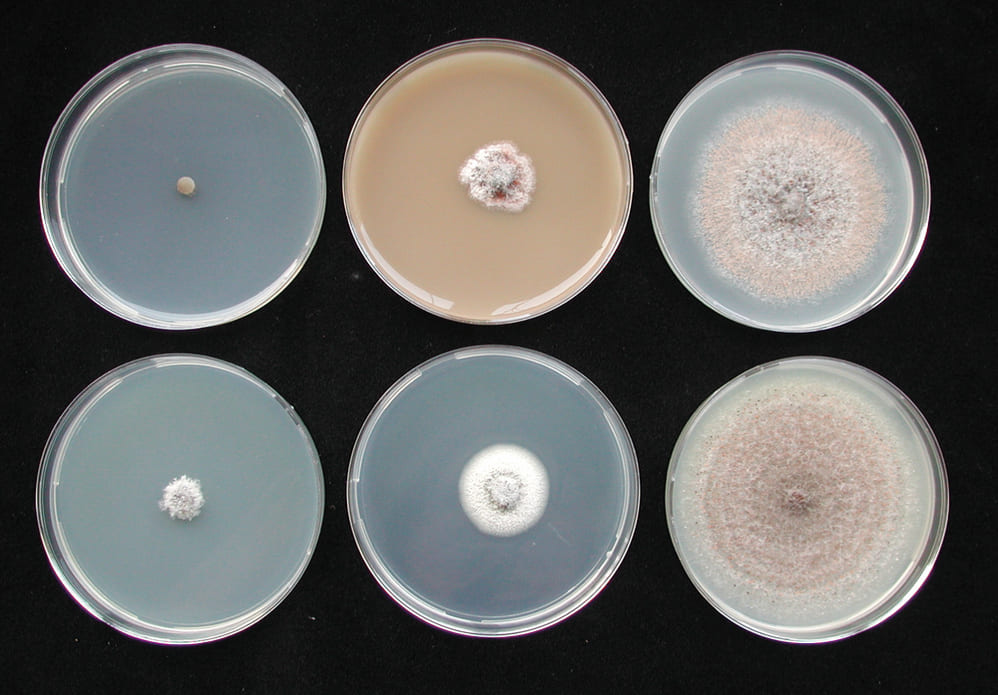

文/王照仁、許晴情 行政院農業委員會臺中區農業改良場助理研究員 圖/王照仁、許晴情 行政院農業委員會臺中區農業改良場助理研究員 劉興隆 前行政院農業委員會臺中區農業改良場副研究員
晚腐病具有潛伏感染的特性,農民往往錯失最佳防治時機,在錯誤時機過度使用藥劑,導致農藥殘留超標的問題。
臺灣地處高溫多溼的亞熱帶,病原菌的擴展相對迅速,葡萄在栽培期間就相當容易受到許多病菌的侵染。依據《台灣植物病害名彙》的記載,目前葡萄作物有13種真菌與類真菌性病害、一種細菌性病害、二種病毒病害,以及多種線蟲種類的侵害。根據本場研究人員多年的調查,「晚腐病」一直是限制葡萄栽培產業的因素之一,對於葡萄晚腐病的防治作法,依農委會動植物防疫檢疫局「農藥資訊服務網」提供的資料顯示,葡萄晚腐病的推薦藥劑種類繁多,共有22種藥劑,且分屬於14種作用機制,而目前農民仍使用化學藥劑防治為多。不過農民防治失當、導致損失慘重的消息仍時有耳聞,因此,本文將針對晚腐病的病原菌特性、綜合管理措施、藥劑種類選擇及適當施用時機加以說明,期盼提供農民更多元且有效的防治選擇。

晚腐病會造成果體軟化最終導致乾腐的情況。環境溼度高時可在果表產生大量橘紅色黏稠狀的分生孢子。
多溼環境易好發 潛伏感染難觀察
葡萄晚腐病是由一種植物病原真菌——炭疽刺盤孢菌屬(Colletotrichum spp.)所引起。目前全世界已發現五至六種可引起葡萄晚腐病的炭疽菌,近年雖已有相關報導探討國內葡萄晚腐病菌的種類(林筑蘋等,2018),並且顯示臺灣葡萄晚腐病菌可能存在二種以上的炭疽病菌,然而臺灣目前的正式報導仍以C. gloeosporioides(中文學名為似膠黏孢炭疽刺盤孢菌,以下簡稱炭疽菌)為唯一引起葡萄晚腐病的病原菌。
炭疽病菌除了可能感染果實,造成果腐病徵外,亦被證實可能感染葡萄嫩梢、葉片及花,產生黑褐色壞疽斑或組織黃化的症狀。葡萄植株自果實採收後、清園至萌芽的這段期間,病原菌可能透過菌絲或孢子等構造殘存在植株上,例如:乾枯的葡萄葉、枝條及芽點處,且在植株組織表面上不一定能看到明顯病徵。
炭疽菌的分生孢子為主要感染原,且可透過風雨散播。該菌已被證實其感染及擴散能力與氣候因子(降雨量和降雨天數)呈正相關(Chakraborty and Billard, 1995),這也解釋了葡萄晚腐病好發於多雨潮溼的環境。而全球性極端急降雨的天氣形態是當前面臨的問題,因此在防治本病害上需要格外重視。
另外,晚腐病具有潛伏感染的特性,也就是說,病原菌在葡萄果實尚未轉色時侵入後不會立即產生病徵,要等到果體進入轉色期,病原菌才會開始擴展、造成果腐的情況。也因此,農民往往錯失最佳防治時機,在錯誤時機過度使用藥劑,導致農藥殘留超標的問題。

葡萄晚腐病在果實尚未轉色前的病徵。

葡萄晚腐病菌在培養基上的菌落形態。
藥劑、套袋與研究:晚腐病的綜合防治
一、多樣性的藥劑防治
針對葡萄晚腐病,國內目前已有22種推薦藥劑可供選擇,為了讓農民更了解藥劑的特性,筆者自其中選擇十餘種藥劑在實驗室進行測試,分析該藥劑對葡萄晚腐病菌菌絲生長與孢子發芽的抑制效果,結果顯示,得克利、腈硫、免得爛及腐絕快得寧具有100%抑制病原菌菌絲生長的能力;撲克拉、得克利、克熱淨及免得爛具有100%抑制孢子發芽的能力。另外,由於病原菌具有透過菌絲殘存於植株或環境中的特性,因此在清園期就可以選擇具有抑制菌絲生長的藥劑進行防治;而在葡萄進入開花期後,田間主要的感染原是病原菌孢子,此時可使用具有抑制孢子發芽的藥劑來防治病害。選擇更多樣且有效的藥劑,可以避免因過度重複使用作用機制相同的藥劑,而造成菌株產生抗藥性。
二、提早進行套袋處理
一般農民習慣在開花後45天再為葡萄套袋,而研究顯示,提早套袋能大幅降低晚腐病感染率。劉興隆等人(2016)研究指出,在葡萄開花後30天內進行套袋,套袋前將藥劑均勻噴溼於果串,再將套袋袋口套於果串的果梗上,最後用套袋的鐵線纏繞、綁牢,避免雨水攜帶病菌孢子流入而造成感染,就能達到極佳的晚腐病防治效果。該研究於彰化溪湖的田間試驗結果顯示,提早套袋的處理組,在60天後皆無觀察到晚腐病的發生,而一般農民慣行栽培的套袋法(開花後45天以上才套袋),晚腐病罹病率已達95.6%。另外在彰化大村的田間試驗結果也指出,套袋處理的區域皆無發生晚腐病,而無套袋處理的區域,晚腐病的發病率則有53.8%。上述試驗皆已證實「提早套袋」可有效降低葡萄晚腐病的罹病率。另外,套袋後就不須再施用晚腐病藥劑,也能降低五成以上的晚腐病用藥頻度,相當於每公頃約可節省9,000元防治費用。

隨意丟棄的病果或落果,都可能成為潛在的感染原。

圖左為本場建議的套袋方式,圖右則是農民普遍使用的套果傘方式。
三、研究非化學藥劑資材
目前用於葡萄病害的非化學藥劑防治資材仍是以亞磷酸為主,亞磷酸透過「提前誘導植株產生抗病反應」以達到保護植株的效果,因此需要在病原菌感染植物前施用。經本場研究人員測試發現,亞磷酸對於葡萄白粉病與露菌病確實有良好的防治效果,然而對於葡萄晚腐病則沒有。然而國內外已有許多報導指出,如芽孢桿菌屬(Bacillus spp.)與木黴菌屬(Trichoderma spp.)具有抑制作物炭疽病菌的能力,代表說此類微生物具有作為生物防治菌的潛力,只是目前國內仍鮮少有針對葡萄晚腐病的研究,應值得在未來持續深入探討。
評估不同藥劑對葡萄晚腐病菌的菌絲生長之抑制效果。透過添加不同推薦藥劑的馬鈴薯葡萄糖培養基,觀察晚腐病菌在該培養基上的生長速度與菌落形態,藉此評估該藥劑對於晚腐病菌的抑菌效果。
防治晚腐病的相應對策與瓶頸
綜合來說,晚腐病於田間的管理策略,建議在葡萄修枝期利用藥劑(例如得克利、腈硫、免得爛或腐絕快得寧)清園以降低殘存於植株或環境表面的病菌密度;在葡萄開花後30天內就提早套袋處理,並在套袋前把推薦藥劑(如撲克拉、得克利、克熱淨或免得爛)均勻噴溼葡萄果串,並確保鐵線纏繞綁牢,避免雨水攜帶病原菌孢子流入果串中。如此即可有效保護果串免受晚腐病菌感染。筆者對本場轄區的葡萄農民進行問卷調查,發現農民已普遍使用套袋來防治晚腐病,只是對於「提早套袋」的接受度仍有不足,推測可能原因為農友來不及於建議時間內套裝完畢,或是自身對提早套袋的認知不足,此狀況和當前農業缺工及農民高齡化相關。期望未來能舉辦觀摩講習會及開發省力機械,於觀念上,提供農民對於晚腐病防治的正確觀念,也在實務面給予農民協助。於研究方面,由於臺灣的葡萄晚腐病菌種類可能已存在不只一種,而不同種的炭疽病菌對藥劑的感受性也有所不同,因此,持續投入相關研究以釐清病原菌的種類並分析對供試藥劑的感受性,對於未來的藥劑選擇能更添益處。
(參考文獻請逕洽作者)
更多文章請見《豐年雜誌》2020年7月號